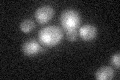
YMR106C
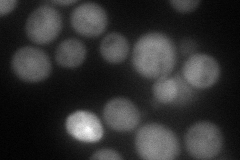
YMR106C
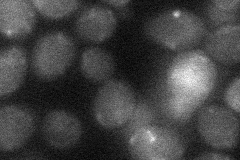
YMR106C
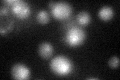
YMR106C
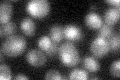
YMR106C
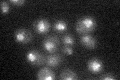
YMR106C

View description
Subunit of the telomeric Ku complex (Yku70p-Yku80p), involved in telomere length maintenance, structure and telomere position effect; relocates to sites of double-strand cleavage to promote nonhomologous end joining during DSB repair
Localization:
Intensity:
Fold change:
Significance:
-
C’ GFP library in SD
nucleus22.27 -
N' NOP1pr-GFP in SD

cytosol,punctate56.561 -
N' TEF2pr-mCherry in SD
cytosol73.3953 -
N' NATIVEpr-GFP in SD

cytosol21.4747 -
N' TEF2pr-VC and Cyto-VN in SD
below threshold22.8488 -
C’ GFP library in SD+DTT
nucleus24.711.1No -
C’ GFP library in SD+H2O2
nucleus23.471.05No -
C’ GFP library in Starvation Media
nucleus24.111.08No -
C’ GFP library on the background of Pup2-DaMP

nucleus -
C’ GFP library on the background of CCT mutant

nucleus24.92431.11877No
